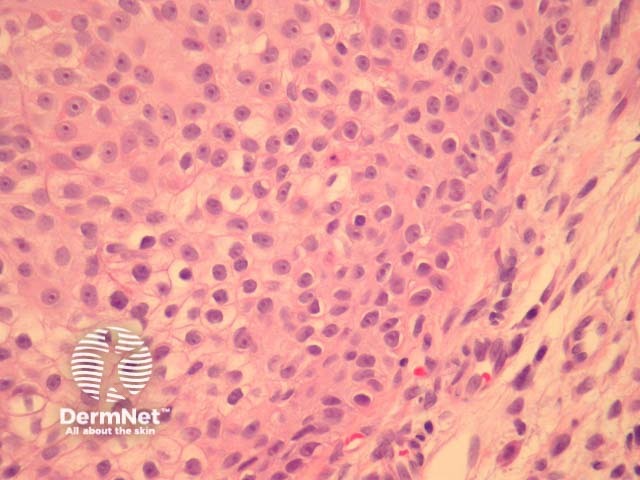
Figure 2

Main menu
Common skin conditions
NEWS
Join DermNet PRO
Read more
Quick links
Lesions (cancerous) Diagnosis and testing
Author: Assoc Prof Patrick Emanuel, Dermatopathologist, Auckland, New Zealand, 2013.
Trichilemmal carcinoma typically occurs as solitary exophytic tumour on chronically sun-exposed skin of older individuals.
Trichilemmal carcinoma is often well defined laterally and is composed of lobules of atypical keratinocytes exhibiting clear cell change. At the periphery of the lobules the keratinocytes show palisading and are surrounded by a prominent connective tissue sheath (figures 1, 2). The invasive tumour front is usually a broad pushing front. The cells often exhibit marked pleomorphism and numerous mitoses (figure 3, 4).

Figure 1
Figure 2

Figure 3

Figure 4
Immunohistochemical studies are of limited utility. Porocarcinoma or other malignant eccrine/apocrine carcinomas should exhibit some ductal differentiation which can be demonstrated with staining for DPAS or immunostaining for CEA/EMA.
Other clear cell tumours need to be considered: